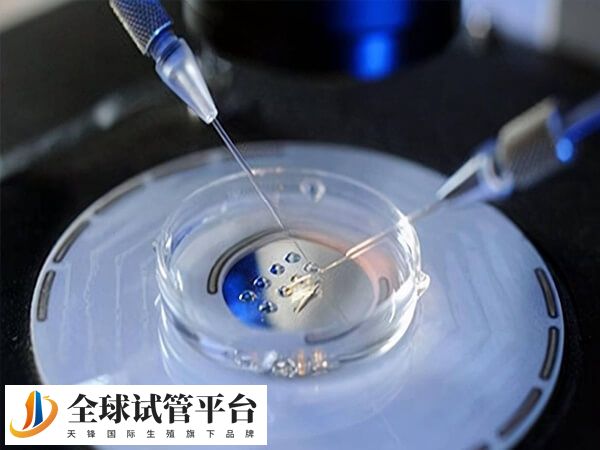

胚胎植入时有什么感觉
简单来说胚胎移植过程,在B超引导下,医生将培养好的胚胎放置在一根非常柔软纤细的移植管中,沿着探好的路线将胚胎精准地放置在宫腔中一个合适的位置,然后撤出移植管。这个过程通常很快,一般没有感觉,但也有比较敏感的人会下腹轻微的疼痛、有针刺感。
胚胎植入时有什么感觉
试管婴儿胚胎移植是其中重要的一个环节。胚胎在宫腔植入时,对子宫内膜会有一个侵蚀过程,会刺激子宫肌肉轻微收缩。部分患者身体较敏感,可能会感觉到下腹轻微的疼痛,如针刺感。也有部分患者因为小血管破裂或者子宫内膜少许脱落,会出现阴道少许淡粉色或者咖啡色的血液流出,一般1~2天后症状消退。
胚胎植入后,着床时大部分的姐妹是没有感觉的,小部分可能会感觉小腹酸酸胀胀的甚至有一丝丝疼痛感,有的可能会出现少量的褐色分泌物,一般不需特殊处理,保持外阴清洁即可。
常见着床成功的表现症状有疲惫嗜睡、头晕恶心、胸部胀痛、体温变化、频繁跑厕所、出血或痉挛症状(轻微粉红色或棕色)等。





